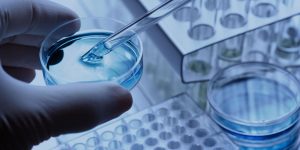

Global Ensayos de apoptosis Mercado 2022 Tamaño Compartir Próximas tendencias Segmentación y pronóstico para 2028
Los factores clave de crecimiento, los desafíos, la segmentación, la perspectiva regional, las principales tendencias de la industria, las oportunidades, el análisis de la competencia, el análisis de impacto de …